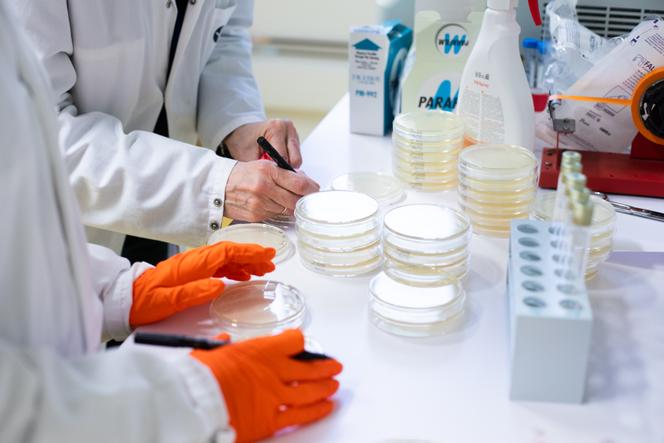

04-12
Le défi du modèle économique des antibiotiques
 2025-01-21
IDOPRESS
2025-01-21
IDOPRESS
Préparation de boîtes de Petri en vue de cultiver des bactéries,dans le laboratoire de l’unité écologie et évolution de la résistance aux antibiotiques de l’Institut Pasteur,à Paris,le 15 janvier 2025. JULIE BALAGUE POUR « LE MONDE » L’équation du marché des antibiotiques est devenue un vrai casse-tête. Comment rentabiliser des investissements en recherche et développement pour des médicaments que les autorités sanitaires appellent de leurs vœux mais dont elles demandent,dans le même temps,d’en prescrire le moins possible ?
Les besoins de nouvelles molécules pour lutter contre les infections résistantes aux traitements vont croissant dans le monde,mais l’industrie pharmaceutique a déserté le terrain. En 1990,dix-huit des cinquante premiers laboratoires étaient sur le marché des antibiotiques ; trente ans plus tard,ils sont deux (Roche et GSK),selon Florence Séjourné,PDG de la jeune biotech lyonnaise Aurobac Therapeuthics.
A côté du sursaut des financements publics observé depuis dix ans sur le sujet dans les pays riches,d’autres initiatives ont vu le jour. L’organisme à but non lucratif Carb-X (pour Combating Antibiotic Resistant Bacteria Biopharmaceutical Accelerator),né en 2016 à la faculté de droit de l’université de Boston (Massachusetts),encourage la recherche et le développement dans les domaines de la prévention,du diagnostic et du traitement des bactéries résistantes. Financé par des institutions publiques et privées,il a apporté 553,2 millions de dollars (537 millions d’euros) à une centaine de projets dans le monde en sept ans.
Il vous reste 71.55% de cet article à lire. La suite est réservée aux abonnés.
Avertissement: Cet article est reproduit à partir d'autres médias. Le but de la réimpression est de transmettre plus d'informations. Cela ne signifie pas que ce site Web est d'accord avec ses opinions et est responsable de son authenticité, et ne porte aucune responsabilité légale. Toutes les ressources de ce site sont collectées sur Internet. Le partage est uniquement destiné à l'apprentissage et à la référence de tous. En cas de violation du droit d'auteur ou de la propriété intellectuelle, merci de nous laisser un message.




